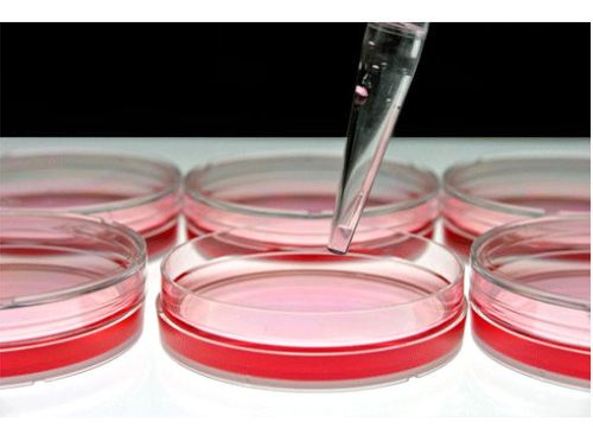

L’Università di Pisa ha presentato il sistema AISAFETY. Servirà ad evitare incidenti sul lavoro legati all’utilizzo delle macchine.
Leggi tutto
Sara Moraca
Un fegato artificiale miniaturizzato costruito con chip microfluidici in silicio per i test farmacologici ha dimostrato che gli organo chip (dall’inglese, organs-on-chip) possono diventare modelli sperimentali attendibili per test farmacologici, e non solo, aprendo la strada ad una possibile eliminazione dell’uso di cavie animali. Lo studio, pubblicato su Advanced Functional Materials e condotto dal team di ricerca del Prof. Giuseppe Barillaro del Dipartimento di Ingegneria dell’Informazione dell’Università di Pisa con la collaborazione del gruppo del Prof. Nico Voelcker della Monash University, ha riguardato lo sviluppo di un modello di organo con strutture tridimensionali che hanno la dimensione effettiva delle cellule epatiche e che sono disposte in modo da replicare anche architettonicamente l’organizzazione delle cellule del fegato nel lobulo epatico.

Il fegato è uno dei più grossi organi del corpo umano, ma l’evoluzione ha fatto sì che si micro strutturasse in unità elementari dette lobuli epatici, una piramide a base esagonale ai cui vertici ci sono vene e arterie, che portano sangue ossigenato, e dotti biliari, che ne eliminano le secrezioni. Quando le vene entrano nel lobulo epatico si chiamano sinusoidiepatici; tra un sinusoidee l’altro ci sono gli epatociti, che disponendosi in cordoni stabiliscono delle connessioni fondamentali per alcune funzioni base del fegato, tra cui detossificazione e il mantenimento dell’omeostasi. “Ci siamo concentrati sulla riproduzione in microscala di alcune caratteristiche del fegato, utilizzando delle nanotecnologie finora utilizzate per la realizzazione di circuiti integrati e microprocessori. In particolare abbiamo cercato di replicare l’architettura dei sinusoidiepatici, in modo da permettere la disposizione degli epatociti in cordoni tra sinusoidi contigui. Gli epatociti vengono quindi nutriti con un sistema di microfluidico. In questo modo, siamo riusciti a mimare l’architettura che gli epatociti hanno nel corpo e a mantenere l’attività e le caratteristiche della cellula più a lungo rispetto a quanto non accada con una normale coltura, un mese invece che una settimana.”, spiega Barillaro. Alcuni test in vitro di tossicità su tre farmaci hanno confermato che gli organi-su-chip del Dipartimento di Ingegneria dell’Informazione riescono a ricreare condizioni fisiologiche molto vicine a quelle esistenti nel corpo umano.

Una delle grandi possibilità degli organochip sta proprio nel poter ridurre o eliminare la sperimentazione animale. Per testare un farmaco, infatti, ci sono 3 stati fondamentali: in vitro, sperimentazione animale, test sull’uomo. La sperimentazione in vitro prevede dei test in laboratorio su uno strato di cellule 2D, che però non permettono di sperimentare l’effetto di molecole su strutture tridimensionali simili a quelle che le cellule formano nel corpo umano. “Le condizioni in cui vivono le cellule in questo substrato piano, sono totalmente diverse da quelle che sperimentano all’interno di un organo: differiscono per stimoli morfologici, fluidici e meccanici”, spiega Barillaro.

Uno dei principali fattori che ha portato all’utilizzo di modelli animali è che, se si lavora su una coltura 2D di cellule, dopo circa 48 ore le funzioni proprie di un determinato tipo di cellula non vengono più espletate. È chiaro che, a queste condizioni, non è possibile condurre esperimenti di alcun tipo. Questo perché le cellule non riconoscono il proprio microambiente e non stabiliscono le interconnessioni tipiche dell’organo. Anche per quanto riguarda la sperimentazione animale ci sono comunque delle limitazioni: lo screening animale di un nuovo farmaco permette di riconoscere solo il 40% dei farmaci che sono tossici per gli esseri umani. Nel rimanente 60% dei casi, la tossicità emerge nel trial clinico sull’uomo e quindi il farmaco non viene immesso sul mercato: questo causa un notevole dispendio di tempo e denaro. Stime statunitensi attestano che i test sull’uomo di un solo farmaco comportano dai 4 agli 8 anni e costi che si aggirano mediamente sui 2 miliardi di dollari.
Le case farmaceutiche erano inizialmente diffidenti rispetto agli organochip, perché li consideravano come un ulteriore test in vitro. Questo perché mancava la biomimetica, ovvero la capacità di riprodurre la microarchitettura dell’organo. Oggi invece l’atteggiamento è molto diverso: alcune grandi multinazionali stanno finanziando startup e stanno inaugurando programmi di open proprio sugli organo chip.

Sia in Europa che negli Stati Uniti, gli studi sugli organo chip sono iniziati circa una decina d’anni fa. La grande differenza sta nel fatto che negli Stati Uniti l’NIH, l’istituto nazionale della salute, ha concesso grossi finanziamenti per le ricerche sull’argomento, mentre in Europa questo non è ancora accaduto. Negli States, ogni istituto di ricerca lavora su un diverso organo chip; l’obiettivo è poi far confluire i risultati dei diversi studi per creare uno Humanchip, che permetterà di riprodurre lafisiologia umana mettendo insieme le diverse microarchitetture degli organi. “Con lo Humanchip sarà possibile osservare l’efficacia del farmaco sull’organo per il quale è stato prodotto e, nel contempo,controllarne gli impatti su tutti gli altri organi”, spiega Barillaro. In Europa si sta cercando in questo momento di costituire una flagship sugli organo chip, che al momento ha passato la prima fase e sarà sottoposta a un secondo step nei prossimi mesi. Alla flagship europea parteciperebbero non solo partner accademici, ma aziende interessate a portare avanti i risultati della sperimentazione.

“Stiamo oggi lavorando ad un nuovo fegato artificiale miniaturizzato che oltre all’architettura dei sinusoidi epatici, permette di mimare anche la microarchitettura del lobulo epatico e la microcircolazione all’interno dello stesso, in modo da avere un modello di fegato ancora più vicino a quello reale” dice Barillaro. “Ci aspettiamo che questo nuovo organo chip permetterà di effettuare test farmacologici con risultati ancora più attendibili e vicini a quelli ottenuti sull’uomo, ma anche di capire come ricreare su chip alcune tra le più importanti funzionalità del fegato per andare verso una medicina personalizzata”.
